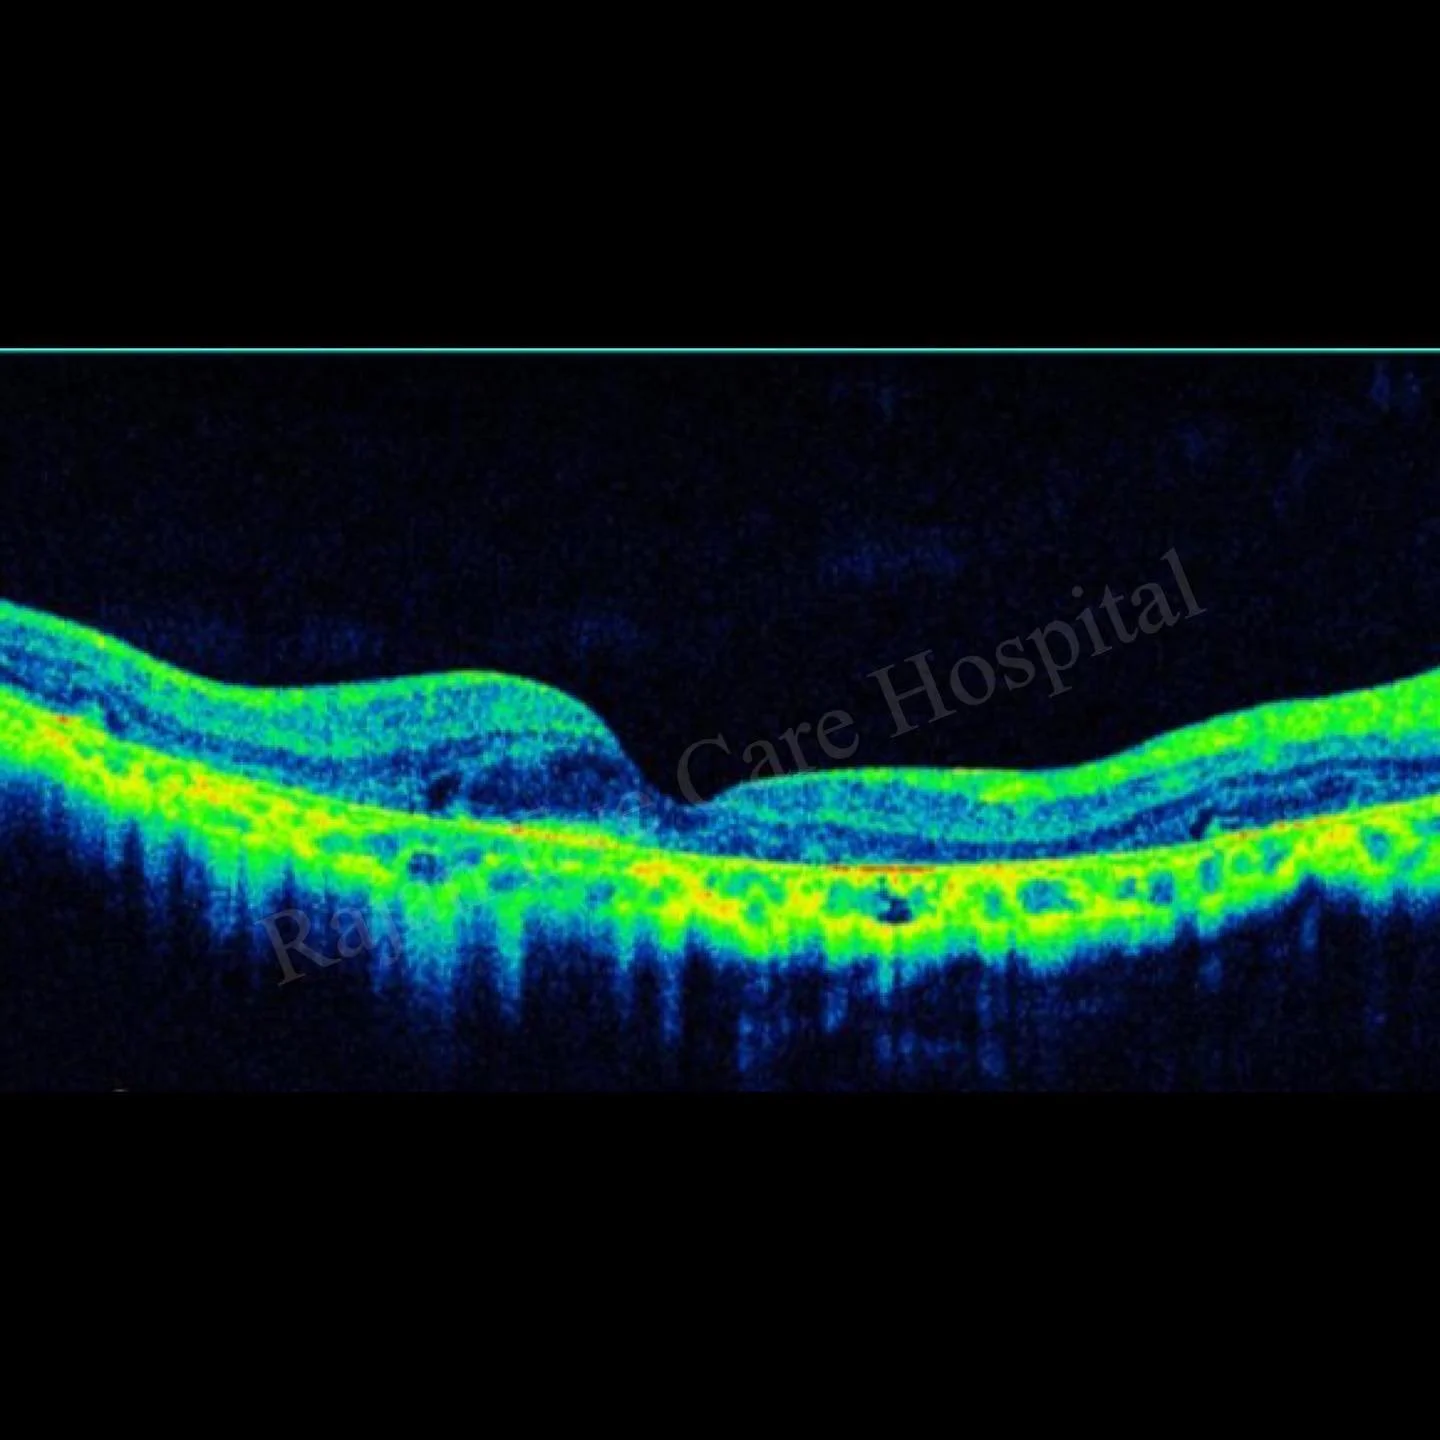

Flecks! Investigations & Management
𝘚𝘵𝘢𝘳𝘨𝘢𝘳𝘥𝘵’𝘴 𝘋𝘪𝘴𝘦𝘢𝘴𝘦 𝘐𝘯𝘷𝘦𝘴𝘵𝘪𝘨𝘢𝘵𝘪𝘰𝘯𝘴 𝘢𝘯𝘥 𝘔𝘢𝘯𝘢𝘨𝘦𝘮𝘦𝘯𝘵
𝙁𝙡𝙪𝙤𝙧𝙚𝙨𝙘𝙚𝙞𝙣 𝘼𝙣𝙜𝙞𝙤𝙜𝙧𝙖𝙥𝙝𝙮:
● Dark choroid sign- Not exclusive to Stargardt disease.
● Due to a lack of early choroidal hyperfluorescence, which is
blocked by high-grade lipofuscin accumulation in the RPE, thus improving visualization of the small retinal capillaries that become easily evident over the dark, non-fluorescent and high-contrast choroid (blockhead arrow)
● Atrophic fovea- choroidal vessels become visible
● Fundus flecks are seen as small irregular hyperfluorescent lesions (arrow). The clinically visible flecks do not necessarily correspond to the window-defects in the FFA.
𝙁𝙪𝙣𝙙𝙪𝙨 𝘼𝙪𝙩𝙤𝙛𝙡𝙪𝙤𝙧𝙚𝙨𝙘𝙚𝙣𝙘𝙚:
● Abnormally increased FAF represents excessive lipofuscin accumulation in the RPE.
● Inversely, decreased areas of FAF relate to low level RPE metabolic activity which normally underlies local atrophy with secondary photoreceptor loss.
● Abnormally high FAF intensity with all other normal parameters suggests that RPE lipofuscin deposition may be the first pathophysiological event in ABCA4-related disease.
𝙀𝙍𝙂 :
● Normal in early disease. Reduced scotopic and photopic responses in advanced cases.
● Slow dark adaptation
𝙊𝘾𝙏 :
● Shows atrophic changes and disorganisation in photoreceptors
● RPE and lipofuscin deposits maybe detected within the parafoveal RPE.
𝙈𝙖𝙣𝙖𝙜𝙚𝙢𝙚𝙣𝙩 :
● No proven treatment.
● Avoid Vitamin A and its supplements- makes the disease worse.
● PUFA such as Docosahexaenoic acid (DHA) shown to reduce toxicity of
A2E ( In autosomal dominant Stargardt)
● Gene therapy
● RPE precursor cells derived from embryonic stem cells injected
subretinally.
Image from Rajan Eye Care Hospital
#ophthalmology#ophthal#doctor#health#medical#vision#education#optometry#medicalstudent#optometrist#medicine#eye#ophtho#ophthalmologist#ophthalmo#med#medicaleducation#ophthalmologyresident#ophthalmologyresidency#stargardtsdisease#maculardystrophy#retina#macular#retinaldystrophy